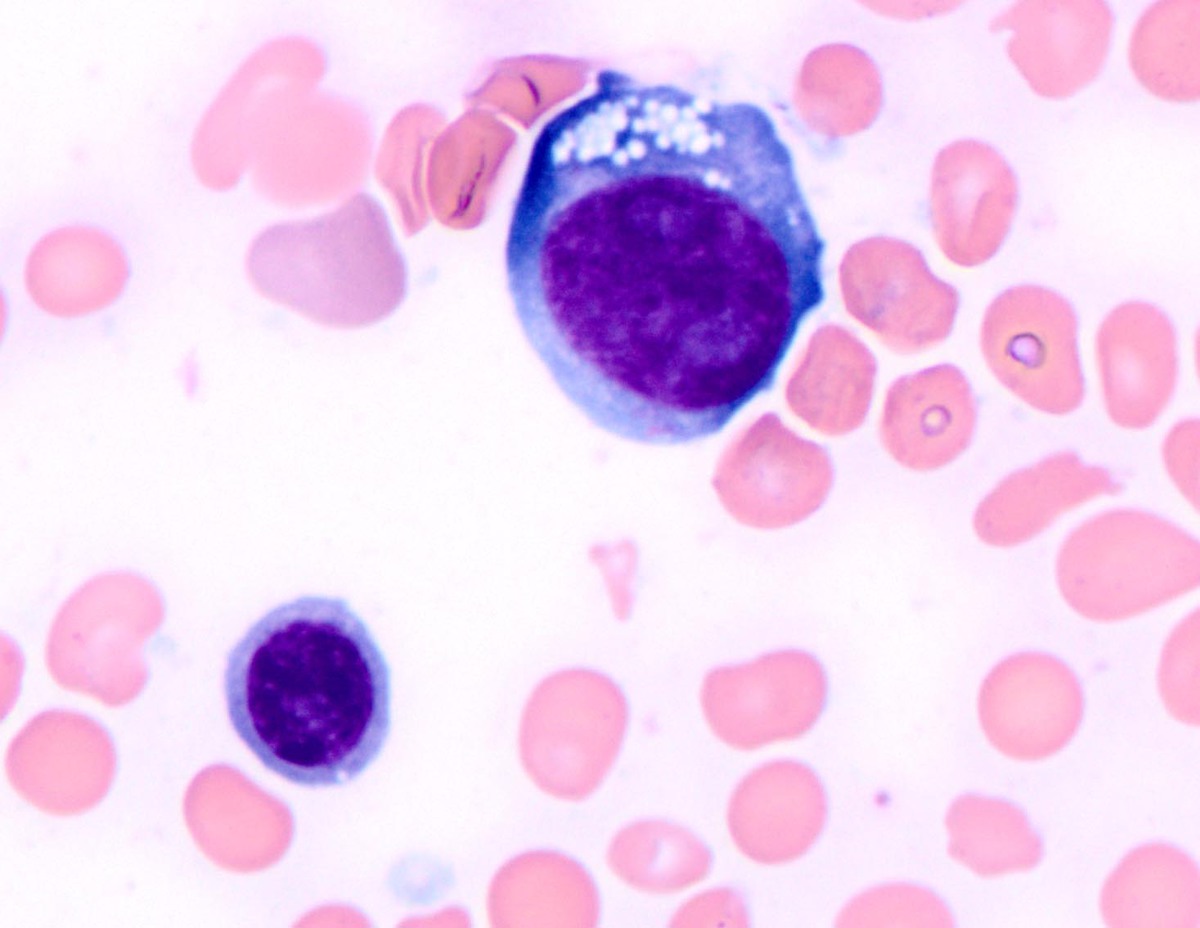
A subset of erythroid precursors shows megaloblastic change and cytoplasmic vacuoles (Wright-Giemsa, 1000x)

Institution: University of Texas MD Anderson Cancer Center
Additional authors:Ellen Schlette, M.D.
Session: AML secondary to myeloproliferative neoplasms and other types of disease progression in MPN
HISTORY
The patient is a 77-year old female with a past medical history of essential thrombocythemia. She was treated anagrelide, hydroxyurea, and busulfan and had a relatively stable clinical course for approximately one year. The patient then developed worsening cytopenias and a bone marrow aspiration and biopsy was performed.
DETAILS
Bone marrow aspirate, clot section, and biopsy were obtained from the left posterior iliac crest using standard techniques. The biopsy and clot sections were fixed in formalin and stained with hematoxylin and eosin after decalcification of the biopsy. The aspirate smears were air-dried and stained with Wright-Giemsa. The peripheral blood showed pancytopenia with circulating blasts, normocytic, normochromic anemia with marked anisopoikilocytosis, polychromasia, and circulating nucleated red blood cells: WBC: 1.0, HGB: 7.1, MCV: 87, Platelet: 27, Neutrophils: 2.0, Lymphs: 88.0, Blasts: 10.0 The bone marrow aspirate contained 82% erythroid cells. Blasts (calculated as percentage of non-erythroid cells) were >20%. The erythroid population showed maturation and dysplastic changes including vacuolated cytoplasm and nuclear membrane irregularities. The granulocyte lineage was severely decreased and showed left-shifted maturation. There were increased blasts with moderate cytoplasm, dispersed chromatin, and prominent nucleoli. The megakaryocyte lineage was severely decreased and showed dysplasia (small, hypolobated forms). Cytochemical stain for myeloperoxidase (MPO) was positive in the blasts. A periodic acid-Schiff (PAS) stain showed marked granular and globular staining in the cytoplasm of the dysplastic erythroids. Blasts 7 % H (0-5) Progranulocytes 0 % L (2-8) Myelocytes 2 % L (5-20) Metamyelocytes 1 % L (13-32) Granulocytes 2 % L (7-30) Eosinophils 0 % (0-4) Lymphocytes 5 % (3-17) Plasma cells 1 % (0-2) Monocytes 0 % (0-5) Reticulum Cells 0 % (0-2) Pronormoblasts 6 % (1-8) Normoblasts 76 % H (7-32) M:E Ratio 0.1 L (3-4) The bone marrow core and clot sections showed a hypercellular (80-90%) bone marrow predominantly composed of erythroid cells and clusters of immature cells with vesicular chromatin and prominent nucleoli.
IMMUNOHISTOCHEMISTRY AND FLOW CYTOMETRY
Immunohistochemical stains were performed on the bone marrow biopsy: CD34: Highlighted a subset of immature cells, representing 2-3% of overall cellular elements. E-Cadherin: Showed faint staining in a subset of immature erythroid cells, with abnormal localization near trabeculae. Flow cytometry showed a myeloid blast population positive for: CD13, CD15, CD33, CD34, CD38, CD45(dim), CD117, CD123 and HLA-DR(dim) and negative for CD2, sCD3, CD4, CD5, CD7, CD10, CD14, CD15, CD19, CD22, CD36, CD38, CD41,CD42b, CD49d, CD56, CD61, CD64, CD71, CD235a, cyCD3, MPO, and TdT
CYTOGENETIC FINDINGS
Conventional cytogenetics showed an extremely complex karyotype:
Hyperdiploid clone
52,XX,+X,del(5)(q22q35),+8,+8,+11,der(12;17)(q10;q10),+13,+19,+mar
Hyperdiploid metaphases
50~53,idem,+1,+19,+mar[cp12]
MOLECULAR FINDINGS
Molecular analysis using next generation sequencing showed a point mutation in codon 273, exon 8 (CGT to CAT) of the TP53 gene and a point mutation in codon 617, exon 14 (GTC to TTC) of the JAK2 gene (V617F)
INTERESTING FEATURES
The patient was treated with Vidaza (hypermethylating agent) and continues to have persistent disease and cytopenias 3 months after the diagnosis. This case contains a large (>50%) erythroid population with some degree of maturation and significant dysplasia. There is also a small myeloid component and increased blasts with a myeloid phenotype. There is also a preceding history of a myeloproliferative neoplasm (MPN) that was treated with busulfan (a bifunctional alkylating agent). The morphologic findings are consistent with Erythroleukemia (erythroid/myeloid) as described in the WHO 2008 Classification System. The preceding history suggests transformation from a pre-existing MPN. The history of treatment with an alkylating agent and the complex karyotype raise the possibility of a Therapy-related Myeloid Neoplasm, however the current WHO classification specifically excludes cases with a previous history of MPN. Previous studies have shown that cases of Erythroleukemia behave in a similar fashion to Myelodysplastic Syndrome (MDS) and that prognosis is more affected by cytogenetic risk score rather than blast count. Given the complex karyotype, this case would be expected to behave as a high-risk MDS. The presence of a TP53 mutation has not been commonly described in such cases and further investigation of its role in such cases may be useful. This case highlights the difficulty in the work-up of a case with ≥50% erythroids and the importance of counting blasts as a percentage of non-erythroid cells so that the patient receives proper classification and risk stratification. It is especially important to differentiate this case from Pure Erythroid Leukemia, which has a much more dismal prgnosis. The presence of a myeloid component as well as maturation beyond the pronormoblast stage in the erythroid population are more consistent with Erythroleukemia rather than Pure Erythroid Leukemia. This case also highlights the need for further investigation of the relationship between prior cytotoxic therapy and transformation of MPN.
PROPOSED DIAGNOSIS
ERYTHROLEUKEMIA (ERYTHROID/MYELOID), ARISING FROM A PRE-EXISTING MYELOPROLIFERATIVE NEOPLASM
CONSENSUS DIAGNOSIS
Myeloproliferative neoplasm/essential thrombocythemia, JAK2 V617F mutation positive, with progression to erythroid-predominant myeloid neoplasm, possibly therapy-related (busulfan)
| Aspirate shows increased erythroid precursors, blasts, and a dysplastic myeloid precursor (Wright-Giemsa, 1000x) | ![]() |
| A subset of erythroid precursors shows megaloblastic change and cytoplasmic vacuoles (Wright-Giemsa, 1000x) | ![]() |
| A subset of erythroid precursors shows globular cytoplasmic staining with PAS (periodic acid-Schiff, 1000x) | ![]() |
| A subset of erythroid precursors shows diffuse cytoplasmic staining with PAS (periodic acid-Schiff, 1000x) | ![]() |
| Biopsy shows a hypercellular bone marrow (hematoxylin and eosin, 40x) | ![]() |
| Biopsy shows increased erythroid precursors and clusters of immature cells (hematoxylin and eosin, 400x) | ![]() |